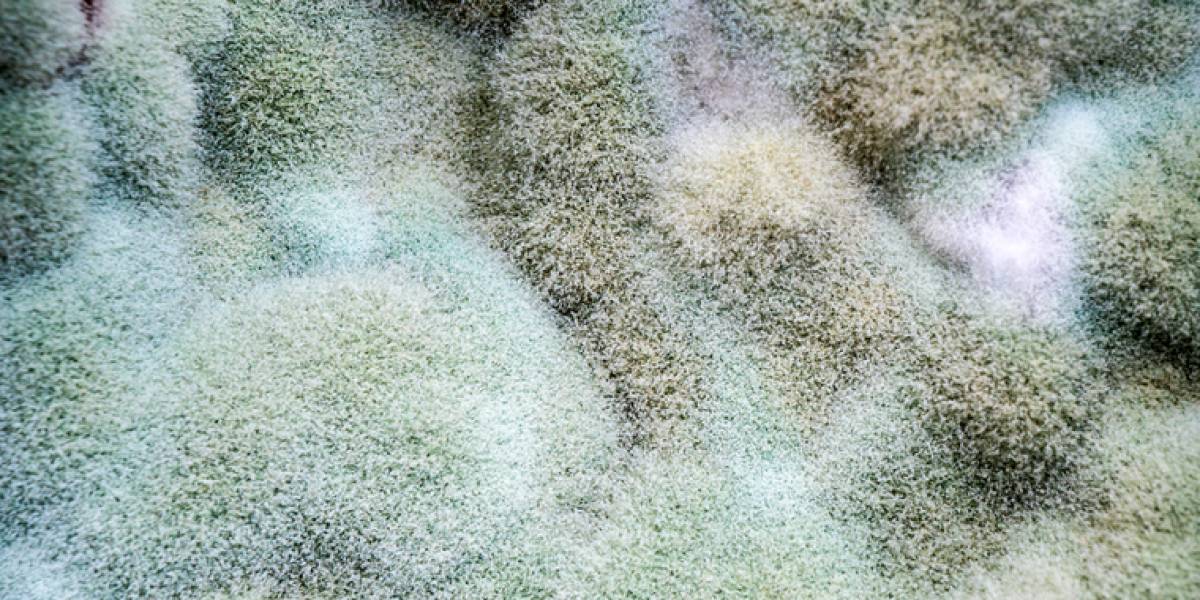

Mange typer madvarer kan udvikle skimmelsvamp. Er det tilfældet, bør man aldrig spise dem. Foto: Shutterstock
De fjernes øjeblikkeligt fra butikshylderne.
Vi har haft nogle varme uger i Danmark, hvor danskerne har indtaget parker og strande på jagt efter solstråler og en bid af det gode vejr. For mange betyder det også, at man medbringer forfriskende forsyninger til, når sulten eller tørsten banker på.
Nu fortæller Fødevarestyrelsen imidlertidig, at man bør tænke sig om, inden man sætter tænderne til en læskende og kold drik. Styrelsen tilbagekalder nemlig - på vegne af Salling Group - to smagsvarianter af frugtdrik, da der er risiko for, at forbrugerne får lidt mere med, end de har betalt for.
Her er de solgt
I pressemeddelelsen fortæller Fødevarestyrelsen, hvorfor det har været nødvendigt at kalde drikkevarene tilbage.
"Der har været tilfælde af skimmelvækst i produktet. Skimmelvækst gør, at produkterne ikke er egnet som fødevarer," skriver Fødevarestyrelsen.
Helt konkret så drejer det sig om disse to smagsvarianter:
- Premieur Frugtdrik med Hyldeblomst/citron
- Premieur Frugtdrik med Hindbær/brombær
- Udløbsdato: Alle datoer
Drikkevarerne er blevet solgt i Nettos butikker.
Slutteligt kommer Fødevarestyrelsen med et råd, hvis man har en eller begge smagsvarianter stående i sit køleskab.
"Fødevarestyrelsen råder forbrugerne til at levere produktet tilbage til butikken, hvor det er købt, eller at kassere det."